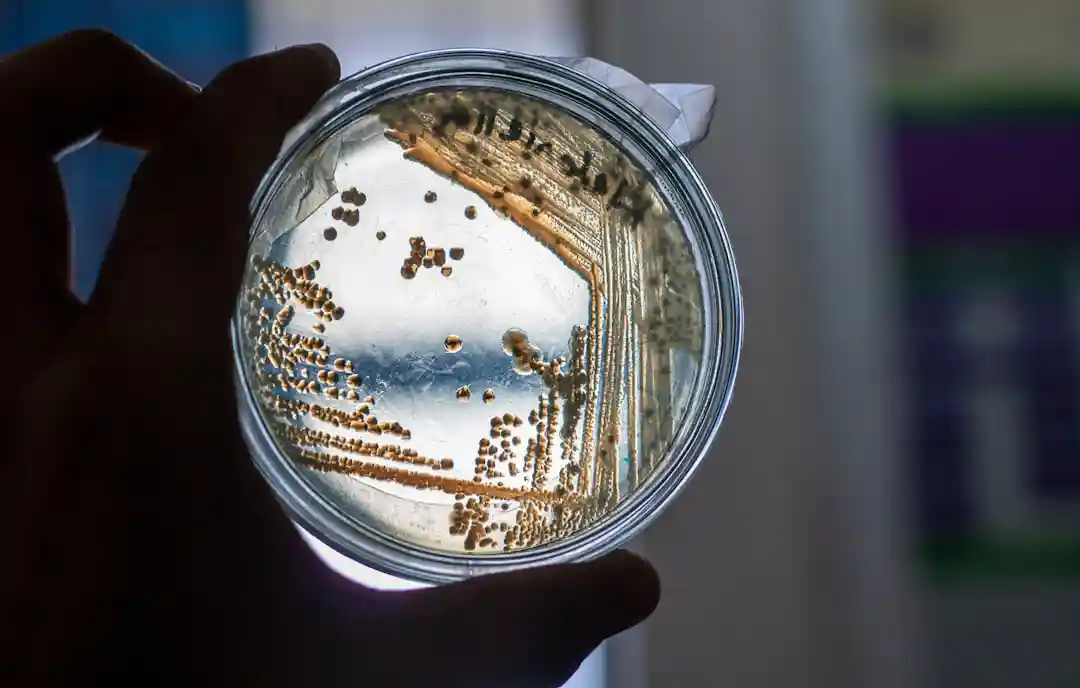
A abordagem interdisciplinar do Caltech, gera ferramentas para diagnósticos mais rápidos e novas terapias, posicionando as instituições como pioneiras no combate à resistência antimicrobiana
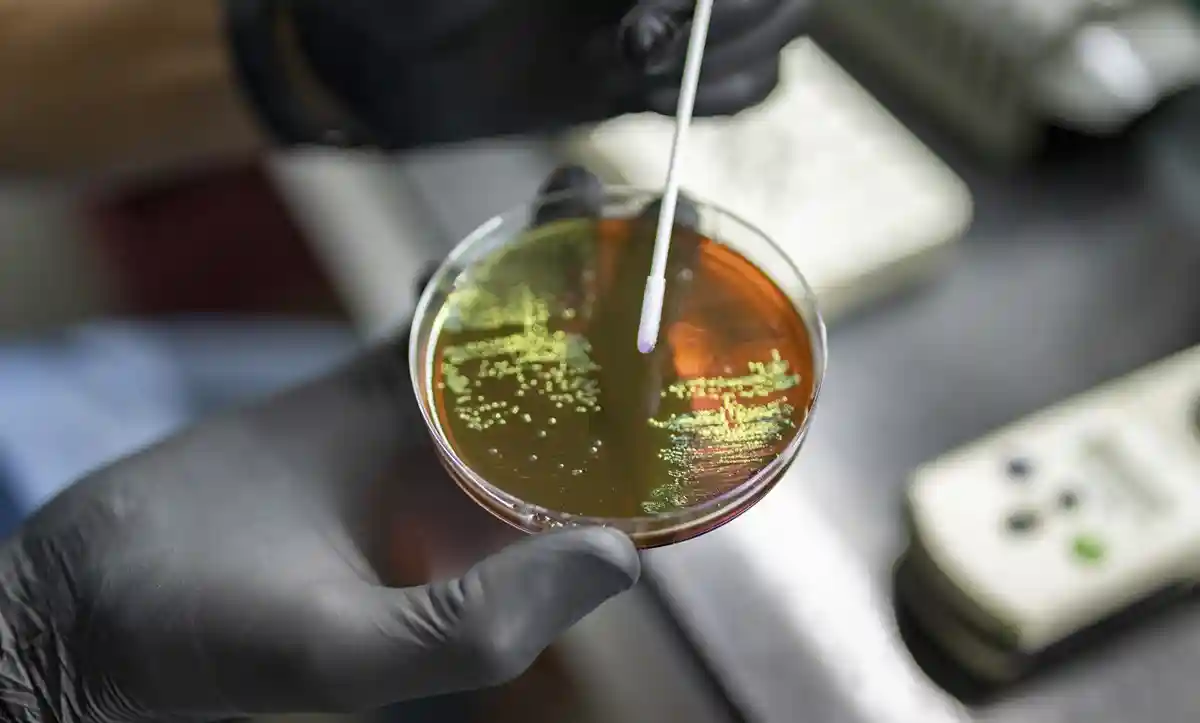
Na OMS/Sarah Pabst,no Instituto Malbrán, em Buenos Aires, Argentina, cientistas estudam amostras de bactérias de toda a América Latina para rastrear e controlar o surgimento da resistência antimicrobiana (RAM).
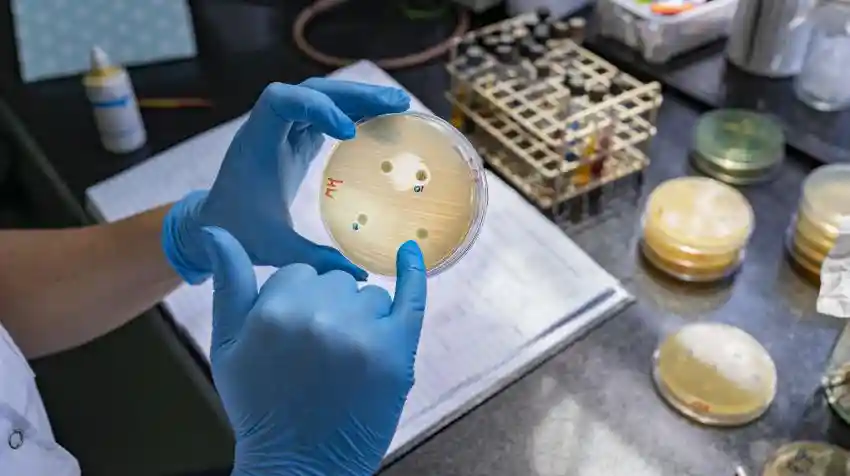
As infecções resistentes a medicamentos não conhecem fronteiras, o que significa que nenhum país sozinho pode combater a RAM

A resistência a antibióticos é uma ameaça crescente à saúde humana e é frequentemente atribuída ao uso clínico excessivo, que seleciona cepas resistentes. Embora muitos antibióticos sejam derivados de microrganismos do solo, a forma como as alterações ambientais nos ecossistemas do solo pode promover a resistência ainda é pouco compreendida. Neste estudo, estabelecemos a seca como um fator determinante da resistência a antibióticos no solo, com consequências potencialmente abrangentes para a saúde pública. Em diversas regiões geográficas e tipos de solo, observamos consistentemente assinaturas metagenômicas de enriquecimento de produtores de antibióticos em condições de seca. Experimentalmente, demonstramos que a redução do teor de água induzida pela seca concentra antibióticos naturais, intensificando a seleção contra cepas sensíveis e favorecendo bactérias resistentes a antibióticos.


Utilizando dados de vigilância clínica de 116 países, mostramos que a frequência média de resistência a antibióticos em hospitais está fortemente correlacionada com o índice de aridez local, mesmo após o controle das diferenças regionais de renda. Em conjunto, nossas descobertas revelam uma ligação pouco reconhecida entre fatores climáticos e resistência a antibióticos.
Leia também
Como o manejo sustentável do pirarucu em Mamirauá multiplicou a renda comunitária e virou modelo global de conservação
Como a castanha do pará depende de orquídeas e abelhas robustas para gerar o fruto icônico da floresta amazônica
Como o poderoso besouro rinoceronte amazônico quebra troncos caídos e recicla nutrientes essenciais para o solo da florestaEsse estudo do Caltech indica que a seca aumenta a abundância de microrganismos resistentes a antibióticos no solo, o que se correlaciona diretamente com o aumento de infecções resistentes a antibióticos em hospitais.
Em outras palavras, regiões com alta aridez — regiões mais quentes e secas — também apresentam níveis mais elevados de infecções resistentes a antibióticos. O trabalho demonstra a interconexão entre clima, meio ambiente e saúde humana.

O estudo foi liderado pelo pesquisador de pós-doutorado do Caltech, Xiaoyu Shan, e conduzido no laboratório de Dianne Newman , professora titular da Cátedra Gordon M. Binder/Amgen de Biologia e Geobiologia. Um artigo descrevendo a pesquisa foi publicado recentemente na Nature Microbiology.
Devido às mudanças climáticas, as secas estão se tornando mais frequentes e duradouras em todo o mundo. Muitos estudos têm examinado como os microrganismos conseguem tolerar o estresse da aridez, mas, até agora, os pesquisadores não haviam investigado o que acontece com os antibióticos naturais do solo durante períodos de seca.
Os microrganismos do solo produzem naturalmente compostos que os ajudam a se defender contra outros micróbios competidores (entre outras funções). Esses compostos naturais têm sido usados por químicos sintéticos como estruturas para a construção de antibióticos clínicos modernos, e o solo é um reservatório natural para a descoberta de novos candidatos a antibióticos. No entanto, da mesma forma que os patógenos infecciosos podem desenvolver resistência a antibióticos clínicos, as espécies bacterianas do solo também podem fazer o mesmo, levando a uma competição em constante evolução.
Para o novo estudo, Shan desenvolveu um programa computacional para examinar conjuntos de dados públicos de sequências microbianas em amostras de solo de todo o mundo, buscando os genes que permitem a produção de diversos antibióticos. Ele e seus colaboradores descobriram que os micróbios produtores de compostos antibióticos são mais abundantes em solos mais secos. Eles levantam a hipótese de que, à medida que o solo seca, o espaço disponível para os micróbios diminui de volume, levando a um aumento no contato de bactérias com os compostos antibióticos, o que as elimina e resulta em um enriquecimento de certas bactérias. Os micróbios que sobrevivem nesse ambiente são aqueles com maior capacidade de resistir aos compostos antibióticos, incluindo os produtores de antibióticos, mas também outras cepas que abrigam genes de resistência.

A equipe então buscou determinar se uma maior presença de micróbios resistentes a antibióticos no solo poderia estar correlacionada com um maior número de infecções resistentes a antibióticos em ambientes hospitalares nessas regiões. Ao examinar conjuntos de dados que rastreavam infecções resistentes a antibióticos em hospitais e comparar esses dados com informações geográficas sobre aridez, eles encontraram uma forte correlação entre maiores incidências de infecções resistentes a antibióticos em hospitais e maior aridez, indicando que a seleção para resistência a antibióticos no solo pela seca pode impactar as populações humanas.
“Estamos em constante contato com o solo, seja por lazer ou simplesmente pela inalação de poeira”, diz Shan. “É importante ressaltar que as bactérias são capazes de transferir genes umas para as outras, e sabe-se que os genes de resistência a antibióticos apresentam uma alta taxa de transferência. Com trilhões de bactérias no meio ambiente, isso representa um evento significativo.”
Newman enfatiza que este trabalho é um exemplo de como o clima, o meio ambiente e a saúde humana estão todos interligados. “As secas estão criando os mesmos efeitos que o uso excessivo de antibióticos na clínica: ambos impulsionam a seleção de resistência a antibióticos”, explica ela. “A impressionante correlação descoberta por Xiaoyu motiva o desenvolvimento de diagnósticos melhores e mais rápidos em ambientes clínicos, bem como o desenvolvimento de novas abordagens terapêuticas”.
A resistência a antibióticos já é um grande problema de saúde pública. A Organização Mundial da Saúde estima que, em 2019, patógenos resistentes a antibióticos causaram diretamente 1,27 milhão de mortes por ano e contribuíram para outras 4,95 milhões. Embora os antibióticos matem microrganismos, os medicamentos usados na medicina também são derivados de microrganismos (ou fungos, como no famoso caso da penicilina).
Patógenos resistentes
Os microrganismos sintetizam antibióticos como parte de uma estratégia evolutiva conjunta com outros microrganismos, visando eliminar quaisquer concorrentes ou ameaças em potencial. Um dos principais campos de batalha dessa guerra evolutiva é o solo.
Newman e a primeira autora do novo estudo, a pesquisadora de pós-doutorado do Caltech, Xiaoyu Shan , descobriram inicialmente um indício de que a seca poderia agravar a resistência a antibióticos em um conjunto de cinco bancos de dados metagenômicos que reúnem informações genéticas de micróbios do solo de diferentes ambientes em continentes ao redor do mundo.
Alguns desses bancos de dados incluíam amostras dos mesmos locais antes e depois da seca.
A equipe planeja agora usar ferramentas de IA para descobrir e compreender os mecanismos que as bactérias utilizam para resistir e modificar os antibióticos.
Nunca perca uma notícia da AmazôniaControle o que você vê no Google
O Google lançou as Fontes Preferenciais: escolha os veículos que aparecem com prioridade. Adicione a Revista Amazônia e garanta cobertura exclusiva sempre em destaque.
Adicionar Revista Amazônia como Fonte Preferencial1. Pesquise qualquer assunto no Google
2. Toque no ⭐ ao lado de "Principais Notícias"
3. Busque Revista Amazônia e marque a caixa — pronto!
















Você precisa fazer login para comentar.